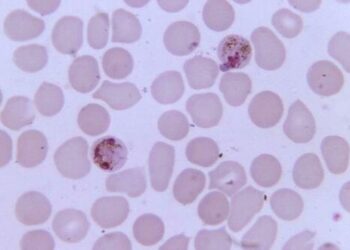
Florida Issues Statewide Emergency Malaria Alert

FINANCIAL
Hundreds Of ‘A-List’ Actors Threatening To Join Hollywood Writers On Strike
Authored by Alice Giordano via The Epoch Times (emphasis ours),A group of 300 A-list Hollywood celebrities—including Ben Stiller, “Hunger Games”...
Read moreThe Sad State Of American Journalism
Authored by Patrick Maines via RealClear Wire,We may never know for sure why FOX News sidelined Tucker Carlson, their most...
Read moreA State Of Martial Law: America Is A Military Dictatorship Disguised As A Democracy
Authored by John and Nisha Whitehead via The Rutherford Institute,“What country can preserve its liberties if their rulers are not...
Read moreIvanka Trump Dropped As Co-Defendant In $250 Million Lawsuit
Authored by Tom Ozimek via The Epoch Times (emphasis ours),A New York appeals court has dismissed all claims against former...
Read moreFlorida Issues Statewide Emergency Malaria Alert
Authored by Jack Phillips via The Epoch Times (emphasis ours),The Florida Department of Health issued a statewide alert after four people...
Read moreCalifornia’s Reparations Task Force Demands Action, Presents 1,100-Page Final Report To Governor, Legislature
Authored by Travis Gillmore via The Epoch Times,After two years of internal discussions, public hearings, and collaboration with stakeholders, California’s...
Read moreThe Power To Define Is The Power To Rule
Truth may be the first casualty of war, but it’s no safer during a pandemic... Source link https://www.zerohedge.com/political/power-define-power-rule
Read moreNew York City Now Sheltering More Illegal Immigrants Than Homeless Citizens: Deputy Mayor
Authored by Ryan Morgan via The Epoch Times (emphasis ours),New York City is now providing more shelter to non-citizens than...
Read moreThe Tide Is Turning On Transgender Tolerance
Authored by Patricia Tolson via The Epoch Times (emphasis ours),Over the past few years, the transgender movement has pushed its...
Read moreRussian Oil Exports From Western Ports To Tumble 18% In July
Is the flood of Russian oil finally tapering?Following several months of record-busting flows, Eikon data showed on Wednesday that Russia's...
Read more